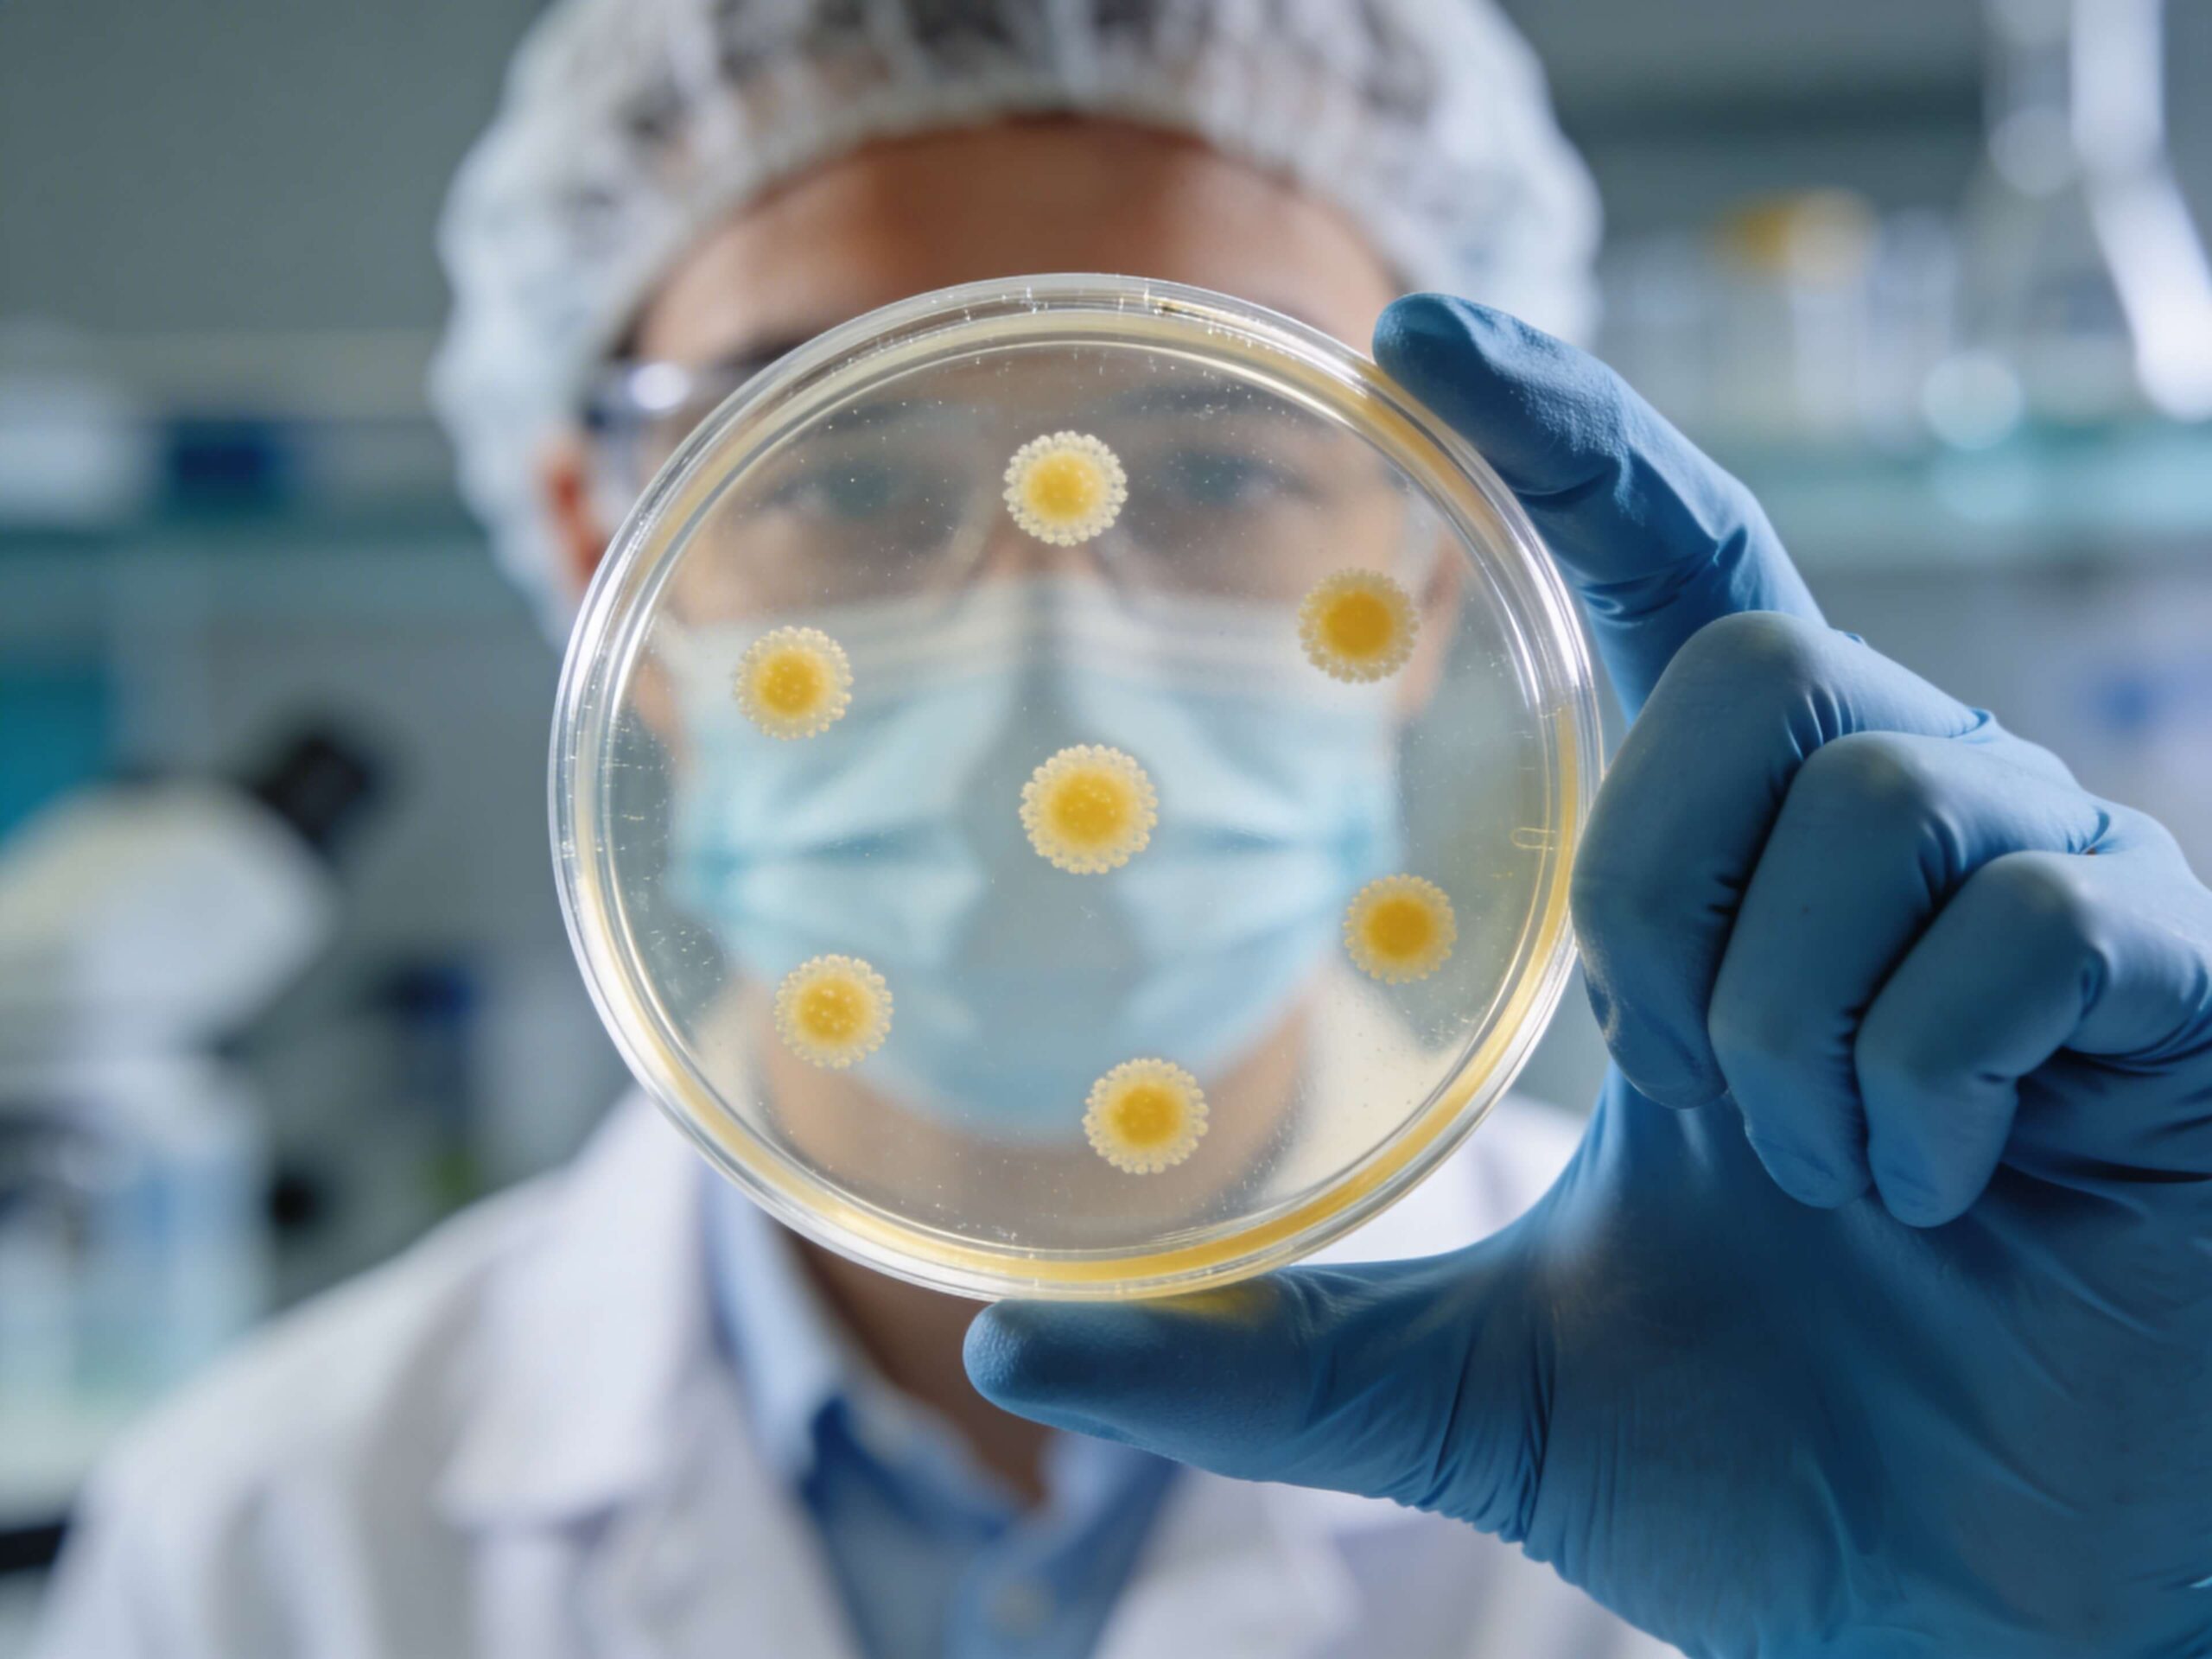

Man-Koso: Anwendung des einzigartigen Naturproduktes
Die Anwendung von Man-Koso ist einfach und lässt sich leicht in den Alltag integrieren. Erfahren Sie hier, wie Sie das fermentierte Produkt anwenden!
In einer Zeit, in der alles immer schneller gehen muss, entdecken viele etwas wieder, das seit Jahrhunderten bewährt ist: die Fermentation. Doch was ist Fermentation eigentlich?
Es ist die Kunst, organische Stoffe durch Mikroorganismen umzuwandeln – ganz ohne künstliche Zusätze. Es ist die Fähigkeit, aus Rohem etwas Neues zu machen – oft mit nichts weiter als Zeit, einem sauren Milieu und dem Ausschluss von Sauerstoff. Und manchmal ist es auch: ein kleines Wunder.
Unsere Wissensseite bringt dir die faszinierende Welt der Fermentation näher – durch Blog, Podcast und ein wissenswertes Lexikon. Weil Verstehen immer der erste Schritt ist.
Im Man-Koso Blog beantworten wir Fragen, die tiefer gehen, wie zum Beispiel:
Du erfährst von anerkannten Experten, wie Fermentierung dein Leben bereichern kann und welche Möglichkeiten diese Methode dir bietet!
Bleibe stets gut informiert und melde dich hier zu unserem Newsletter an!

Die Anwendung von Man-Koso ist einfach und lässt sich leicht in den Alltag integrieren. Erfahren Sie hier, wie Sie das fermentierte Produkt anwenden!

Fermentiertes Gemüse ist besonders bekömmlich und wertvoll. Welche Sorten eignen sich für die Fermentation? Die Antwort und Tipps finden Sie hier.
Welche fermentierenden Bakterien gibt es? Welche Aufgaben haben sie und was bringt Fermentation? Erfahren Sie hier mehr dazu!

Für die Verdauung sind Enzyme von entscheidender Bedeutung. Welche Aufgabe sie haben und worauf Sie achten sollten, erfahren Sie hier.
Im Man-Koso Podcast sprechen wir mit Menschen, die sich mit Fermentation, Ernährung und Kultur beschäftigen. Entdecke interessante Episoden von Ernährungsexperten! Informiere dich über die Zusammenhänge von Fermentation und Wohlbefinden! Entdecke einen neuen Lebensstil und lass dich von Experten unterstützen!
Wir wollen zuhören, verstehen und neu verbinden – mit den Ursprüngen unseres Essens.
Du möchtest keinen Podcast verpassen? Melde dich hier zu unserem Newsletter an!
In unserem Fermentierungs-Lexikon findest du Klarheit statt unverständlicher Theorie. Von der richtigen Lagerung bis zur Rolle von organischen Stoffen – du bekommst Antworten, die du wirklich brauchst. Ob du gerade erst anfängst oder schon seit Jahren fermentierst.
Für alle, die tiefer einsteigen wollen oder einfach nur verstehen möchten, was da eigentlich im Glas passiert, wenn man Gemüse stehen gelassen hat und sich etwas völlig Neues entwickelt.
Bleibe stets gut informiert und melde dich hier zu unserem Newsletter an!
„Was ist Fermentation?“ – Diese Frage beginnt oft mit Neugier. Doch sie führt zu viel mehr: zu Respekt. Zu Ehrfurcht vor dem Unsichtbaren. Zu einem neuen Verständnis von Leben.
Denn Fermentation ist Transformation. Von Lebensmitteln. Von Gedanken. Von Gewohnheiten.